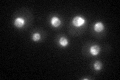
YFR001W
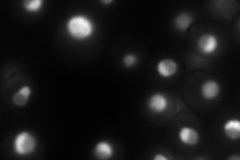
YFR001W
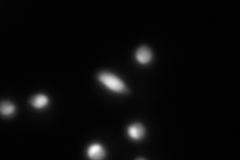
YFR001W
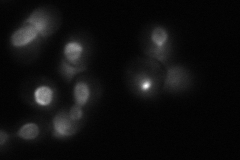
YFR001W
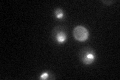
YFR001W

View description
Nuclear protein involved in asymmetric localization of ASH1 mRNA; binds double-stranded RNA in vitro; constituent of 66S pre-ribosomal particles
Localization:
Intensity:
Fold change:
Significance:
-
C’ GFP library in SD
nucleus52.01 -
N' NOP1pr-GFP in SD
nucleus,nucleolus158.269 -
N' TEF2pr-mCherry in SD
cell periphery,vacuole0 -
N' NATIVEpr-GFP in SD
nucleus,nucleolus86.4048 -
N' TEF2pr-VC and Cyto-VN in SD

nucleus,nucleolus52.713 -
C’ GFP library in SD+DTT

nucleus41.340.79No -
C’ GFP library in SD+H2O2
nucleus43.980.84No -
C’ GFP library in Starvation Media

punctateN/AN/AYes -
C’ GFP library on the background of Pup2-DaMP

nucleus -
C’ GFP library on the background of CCT mutant

nucleus52.61941.01165No
